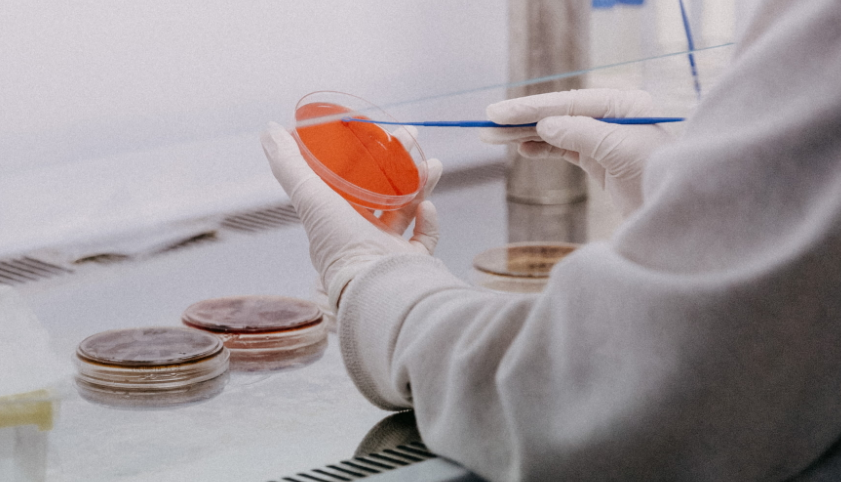

文|动脉网
直到坐在对面的科学家创业者签下TS(投资意向书)后,李林霖悬着的心才总算落地:这是一个她不得不拿下的项目。
“之前好几个我们先跟进的案子,还在走尽调流程,就被半路杀出的投资机构用更高的价格抢走。”在行业里摸爬滚打6年,来自北京的投资人李林霖直言从未如此焦虑过。“大老板下了‘死命令’,这个case(项目)只许成功,不许失败。”
李林霖所在的VC,于几年前从TMT领域转向医疗大健康,相继投中了不少成长性不错的科学家项目,算是较早吃到红利的那波机构。但自从去年医疗领域科学家创业潮明显升温后,李林霖的压力变大,她常常碰到其他投资机构为了争抢到项目,会将价格翻倍的情况。
“科学家创业项目估值一下水涨船高,竞争变得异常激烈,投资机构们的压力自然陡增。甚至大家都在笑称教授和大专家不够用了。”李林霖表示,一位跟她关系要好的某头部VC的投资经理,甚至花了大半年时间飞往全国各地去认识各个科研院所的大专家,以方便在他们决定创业时顺利拿到早期份额。
而随着市场热情的持续高涨,越来越多的科学家和教授主动或被动地走出象牙塔出来创业。
“从我们机构的观察来看,在生物科技领域,越来越多的科学家在下场。”经纬创投合伙人喻志云告诉动脉网。
红杉中国合伙人杨云霞也对此感受明显,这段时间她接触到的科学家和教授创业者相比前几年增加了好几倍。
投资机构们的蜂拥,以及越来越多的科学家和教授们走向产业端,无一不在表明:科学家在医疗领域创业的大时代正在来临。
从数据中便可一窥热度的提升。根据动脉橙果局统计,我国医疗健康领域今年上半年共发生121起早期投融资事件(文末附具体名单),远超去年同期59起早期投融资事件。在上半年融资的121家初创企业中,76%的创始人都是科学家背景。

医疗领域早期融资企业创始人画像 动脉网制图
但超高热度下,不少行业人士对科学家创业项目保持着质疑。
“现在在科学家群体里面流传一句话,叫PI—IP—IPO。什么意思呢?就是我作为一个PI(学术带头人),就要有一个IP(创业项目),最后还要有个IPO(上市)的企业。大家形成了一种攀比的风气。”资深投资人杨锋表示,“这使得当下的科学家项目鱼龙混杂,质量良莠不齐,且部分是专门TO VC的。”
除此之外,不少业内人士皆表示,科学家不是企业家,绝大多数科学家很难成为好的管理者。另外,也有一些科学家不愿全职出来创业,但还要求占据公司的大股,这使得科学家创业项目缺乏好的公司治理体系。
面对热潮与质疑,科学家创业如何才能引领行业大发展?还有哪些问题需要厘清?又需要各方怎样的助力?
为此,动脉网对薄荷天使基金、博远资本、创新工场、鼎晖投资、红杉中国、经纬创投、蓝驰创投、启明创投、松禾资本、元生创投(排名根据拼音顺序)十家一线投资机构进行了调研,并访谈了多位科学家创始人,从中一窥当下的挑战与未来趋势。
VC疯狂押注,但不是每一个科学家都适合创业
科学家正在被疯抢。
从去年年初开始,大量的投资机构开始寻找教授和科学家主导或参与的项目,热闹的时候甚至出现几十个机构疯抢一个教授项目的罕见景象。
“为什么大家要去找科学家?原因在于现在低垂的果实或者源头的创新不足了。”资深投资人杨锋表示,“比如国内目前的研发主要聚集在热门靶点上,其中PD-1靶点的临床试验数量更达到了近100项,同质化严重。又比如在适应症上,大家都挤在抗肿瘤和抗感染等领域。这些都是因为源头创新缺乏。”
正是在此背景下,寻找到更多优秀的科学家,将他们从实验室推向创业场再走向上市,成为了当下的热点。
“早期投资往往是技术驱动,研发能力是核心竞争力,科学家刚好代表了核心技术,他们本身具有原始创新的能力。”鼎晖投资创新与成长投资高级合伙人高洁亮表示。
但科学家是否适合出来创业在行业里却颇具争议。在几年前的一次演讲中,时任清华大学副校长的施一公如此表示,“人不可能一边做大学教授,一边做公司的管理人员,一边还要管金融。”
施一公的话不无道理。实际上,科学家或教授的创业路途十分艰难,且失败的案例比比皆是。从两个指标数据便可看出。
一是低转化率。虽然我国从2019年开始,在专利数量上已连续三年排名全球第一,但关键的转化率仅为5%,与欧美国家差距巨大;
二是高失败率。根据技术转移公司美国巴士底的数据,在美国,高校教授创业失败率高达96-97%。拥有完善创新转化体系的美国尚且如此,处于起步阶段的中国在这一数据上只会更高。
启明创投合伙人陈侃分析,科学家的强项是在实验室不断创造突破性的科学成果,而将这些突破性的转化成果转化为能够治疗病人的产品,是完全不同的技能,因此没有必要一定要科学家放弃他们擅长做的事情来全职做创业。
“目前科学家创业有两种不同的形式,一是自己全职创业,二是担任科学顾问支持创业项目。”松禾资本创始合伙人罗飞告诉动脉网,与传统的创业逻辑不同,科学家群体创业既要解决前沿的科学问题,还要找到商业实现的路径问题。
多位行业人士对此表示,在他们的观察中,不是每一个科学家都适合创业,科学家全职出来后成功的案例并不多。
因此,对于绝大多数科学家来说,找到匹配的创业合伙人才是更优的路径选择。
“科学家的思维聚焦在创新性上,主要从事创造性工作,而创业合伙人更加关注创新技术转化的实用性。”圆因生物CEO汤晓东博士表示,“创业合伙人可以帮助科学家分析市场需求、完成临床挑战和资源整合,另外维护公司正常的管理和运营,帮助团队从0走到1。”
不过当下的情况是,国内的创业合伙人还比较缺乏。

科学家创业路径 动脉网制图
“那些有成功创业经验的行业老兵或Professional CEO是十分稀缺的。”博远资本创始合伙人陈鹏辉表示,“科学家和教授创业,技术不是最大的问题,人才是最大的问题。人才能把技术变成产品,也能把产品变成销售。因此对于投资机构来讲,怎样帮企业找到创业合伙人就成了重要能力。”
在动脉网的调研中,大多投资机构都持相同观点:一个优秀的创业合伙人十分难寻,他们绝大多数已经在产业界拥有不错的职位和薪水,所以要让他们参到早期项目中颇具挑战。这里面涉及项目吸引度、股权分配、团队结构等一系列考验。
基于此,一场探寻创业合伙人的征途开始在科学家项目中逐渐展开。
寻找创业合伙人
“找合伙人比找老婆还难!”有科学家如此感叹。
这是在于,尽管职能上创业合伙人与职业经理人有雷同之处,但两者之间存在本质区别。职业经理人说到底还是企业的雇员,但创业合伙人是科学家在创业路上的亲密战友与伙伴。
简单来说,职业经理人可以在企业与企业之间横跳,但创业合伙人则与创业项目属于利益共同体——他们是与科学家一起经营自己的事业。
“创业合伙人千人千面,每个项目碰到的创业合伙人的情况也都不太一样,有时候是取决于在那个时间点能碰到什么样的人。能把项目推动起来的那个人是最合适的。”薄荷天使基金合伙人侯剑表示。
所以,如何在合适时间点找到合适创业合伙人是科学家和投资机构们最为关注的问题之一。博远资本创始合伙人陈鹏辉对此深有感触。
2016 年,彼时还在红杉中国担任合伙人的陈鹏辉参与了基因检测平台企业NuProbe的天使轮投资。作为典型的科学家创业项目,NuProbe的两位创始人是美国大学教授,刚起步时二人都没打算辞职。
“投资的时候,两位教授给我安排了个任务,帮忙给项目找一个CEO,以帮助技术落地。”陈鹏辉回忆道,“后来我就帮他们找了凯杰公司亚太地区的总裁施晨阳博士,他拥有丰富的商业化经验,且对NuProbe也十分认可,就答应做共同创始人出任过渡型的CEO并联手投资,让公司能够往产业化的方向不断迈进,这解决了企业初期发展的问题。”
但任何一个公司要想全速快跑,CEO必须得是全职的。
于是NuProbe在两年时间里取得快速发展后,就迫切需要一个全职CEO。两位教授创始人和施晨阳博士再次找到此时已创立博远资本的陈鹏辉,希望其能为公司物色合适的人才。
此时陈鹏辉想到了阅尔基因的创始人柴映爽,他是前Life Technologies中国区销售总监,前Thermo Fisher中国区临床市场战略总监,在基因行业有近20年的行业积淀和丰富的市场运营经验。阅尔基因整体运行良好,但NuProbe的技术优势可强化阅尔基因的市场壁垒,并为阅尔基因带来飞跃。
经过撮合认识,NuProbe的两个教授从美国飞过来与柴映爽当面聊。在陈鹏辉的回忆中,整个沟通的过程一开始就像谈恋爱一样,双方一见钟情,非常认可,后面谈的也很投机,许多细节问题都能顺利达成一致, 最后决定两家公司合二为一。Nuprobe和阅尔技术加市场互补,是快速转化技术到市场的非常好的组合。
在合并的过程中,如何确定两家企业的估值,以及如何分配核心管理层的股权等问题成为了摆在陈鹏辉面前的难题。
“无论是NuProbe的三位共同创始人,还是老柴(映爽),他们在股权的问题上都非常大度,对公司未来的发展和各自扮演的角色高度一致,这直接促使两家公司的顺利合并。”陈鹏辉表示,合并后的阅尔基因发展迅速,每年以100%的速度增长。“投资人就是这样,不仅要扶上马,还得送一程,再送一程。”
帮助科学家找到创业合伙人也是红杉中国合伙人杨云霞的工作之一,她近期接触了一位扎根在脑科学领域的知名科学家。
“我们跟他聊了之后,双方都很认可。但他同时也表示自己不会全职出来创业,于是红杉做了两件事,一是拉了业务、法务、人力资源等各个部门开了个会,商讨如何去帮助这个科学家从零到一把项目做起来;二是帮他在我们积累的人脉圈里找CEO人选。”杨云霞告诉动脉网,最后找到的这个CEO大家都觉得非常理想。
而在经纬创投,喻志云透露内部有专门按行业设立投后招聘小组,团队成员平均有超过10年以上的人力资源管理经验,帮助被投企业人力资源建设,给予科学家背景的创业者以支持。
除了投资人牵线搭桥外,同学和同学、老师和学生互相组成创业团队在科学家项目中也极为普遍。
以鹍远生物为例,其创始人张鹍教授和高远教授是哈佛医学院博士后同学,联合创始人兼首席技术官刘蕊博士是张鹍教授的博士后,联合创始人兼CEO张江立是张鹍教授在复旦大学时的本科同学。
“张鹍教授一开始就很明确是自己在项目中扮演科学顾问的角色,而不是作为运营者。”鹍远生物的投资方松禾资本创始合伙人罗飞表示,“CEO张江立在产业里拥有丰富的商业化经验,他在赛默飞世尔科技担任过大中国区医疗业务总经理,并获得过2012年度全球CEO奖。这样的一个团队组合是支撑鹍远生物能取得迅速发展的重要原因。”
可以发现,能找到合适的创业合伙人,对于科学家们来说会少走很多弯路,也会大大提高创业成功率和缩短成功时间。
但同时,在国内有很多科学家创业者对创业合伙人并不完全信任和放权,他们在不全职的情况下占据着比较重要的股权,同时对公司又有着比较大的影响力。这些是当下科学家项目发展过程中普遍面临的难题。

科学家项目寻找合伙人 动脉网制图
股权分配,科学家创业的重要命题
股权分配,往往是科学家创业项目遇到的重要命题。
2019年,在西部某知名大学附属医院担任学术带头人的张铭耀教授决定创业。在搭建初期团队时,张铭耀教授拉来了自己的三位学生做CEO和管理层,在股份上张铭耀教授占比为70%,给其他人设立了股权池,占比22%,剩余的8%股权留给了学校。
项目在刚开始时,张铭耀教授主要出技术和资源,三位学生则全职负责公司日常的运营。
凭借着技术的领先性和优质的院校资源,以及潜在的巨大市场应用空间,项目很快取得了不错进展:在发展的第二年(2020年),项目就火爆到数十家机构前来拜访,高峰时张铭耀教授一天之内要见完15家投资机构,有的是线上,有的是线下。
但随着拜访的投资机构越来越多,项目的估值也水涨船高,内部对股权的划分也开始有了一些争议:三位负责公司日常运营的学生认为自己付出的与实际得到的不成正比,希望能占据更多股份,遭到了张铭耀教授的拒绝。
而对于投资机构,他们也没有在拜访张铭耀教授之后得到他们想要的结果,因为张铭耀教授显得过于“强势”,尤其是在具体的交易金额上面,张铭耀教授完全不退让,只认定一个价格,即便有些投资机构出到一亿估值,张铭耀教授仍不为所动。最后融资失利,张铭耀教授的项目经历了一段时间的现金流危机。
对此,多位行业人士皆认为,在科学家项目的团队构建中,不全职的科学家一定要对自身角色定位清晰,将股权匹配到真正付出更多时间在项目里面的合伙人们,方能实现1+1>2的效果。
“我国科学家项目的股权结构分配还不太成熟。”资深投资人杨锋表示,在中国,众多高校科学家都是项目的实控人,在项目进行到A轮或B轮融资时,其持股比例还能达到30%-40%,而国外高校教授的这一比例大多低于10%。
因此,进行良好的股权结构设计就显得尤为重要,这里面往往涉及组织架构、人才密度等多个方面的事宜。
具体来说,在组织架构层面,首先需要解决的是创业合伙人之间股权是如何分配的问题。“股权的分配没有绝对的定式,但我们的建议是科学家要有开放的心态,让对公司长期发展有利的人占有更多的股权。”创新工场执行董事暨前沿科技基金总经理任博冰表示。
人才密度层面,科学家项目要注重通过设计合适的股权激励计划扩大企业的人才密度,从而带领公司走得更远。比如项目初期一般都是科学家控股,或者担任第一大股东,其合伙人占据几个点到十几个点的股份。在此之外,要设一个股权池,将其他人的股权放股权池里,从而激励后续加入的管理层,实现通过动态的机制来确保持续的公平激励。
有了股权的进入、退出、增减机制,就能有效激励人才和应对极端情况。
操作方法上,滚动授予、取消收回、回购条款等都是比较好的工具措施。企业在不断发展的过程中会发生很多变化,内外部客观环境、早期的联创发展能力和新老人之间的不平衡,创始团队理念不合拍等特殊事件都有可能发生。
“股权问题的实质,就是人性问题。股权分配不好,会成为科学家创业项目成长路上不定时爆发的雷。”资深投资人杨锋表示。
火力全开,投资机构们如何寻找并赋能科学家项目?
随着越来越多的科学家和教授参与到创业大潮中,投资机构们可选择的项目正变得越来越多。
但如何选到真正具有产业化能力的项目和团队仍然是投资机构们的必修课。
“真正能够走得很远的项目其实并不多。”资深投资人杨锋告诉动脉网,科研项目能够产业化至少要满足两个条件,一是这项技术可以放大,实现规模化生产,二是要考虑成本的问题。“这两个条件就可以筛掉很多科研转化项目。”
不仅如此,由于科研项目处在早期,不确定性大,风险也很高。
“技术越前沿意味着投资风险也就越大,在国外,早期基金是由家族基金或者大学基金支撑起来,它没有期限且对项目转化保持低期待的心态。相反,投资机构对于早期项目的期待程度就比较高。”元生创投合伙人李克纯表示。
那在项目的对接上,投资机构们是如何触达到科学家的?
针对此,蓝驰创投合伙人曹巍认为,朋友推荐是一个重要的渠道来源。“在整个行业中,我们会有人脉和朋友圈积累。再有一个是平台的互动,包括一些赋能和行业活动;第三个就是行业研究方面,积极参加行业内的展会;第四是扩展,主动结交关键人。”
而在项目的选择和赋能上,每家机构都有侧重。
例如蓝驰创投从整体上来讲更强调跨学科的、喜欢有交叉领域的创业团队,且希望团队能够足够地开放,愿意去接受一些新的碰撞。另外,创业团队要有非常强的底层能力,这是因为在医疗侧或者是医疗服务这个创新领域中,质量、效率和普惠是考核技术的重要标准。
“质量代表了临床侧高标准的要求,即和临床需求紧密结合,达到非常好的治疗效果;效率是产品或者服务的交互效率高,不能通过复杂的运营或者交互方式传递给患者;普惠主要是和价格相关,在国内,医保具有非常强的议价能力,如果产品未来能跟医保合作,就有足够好的利润空间。”蓝驰创投合伙人曹巍表示。
经纬创投合伙人喻志云更看重的是创始人的全面性,以及团队的互补。创始人不仅要懂技术,还要转型为合格的企业家,比如掌控好公司的发展节奏,懂得做商业决策,对组织架构的设计足够重视等等。“我们医疗投资团队很多也是科学家出身,转型在商界做了很多年,配合经纬一直以来在投后赋能层面的全面动作,所以我们可以以过来人的身份帮助科学家创始人更加全面,帮助团队更加全面。”
另外,经纬内部也十分重视“三化”,即投资生态化、投后场景化、品牌战略化。在投后环节,给被投企业提供包括前置诊断、产业链协同、紧急医疗、尽职调查小组前端赋能、创业生态社区运营等6大模块的支持,以及持续举办‘经纬科创汇’,对创始人在创业中遇到的问题进行场景化梳理,如股权期权、融资、商业模式、人才培养、组织架构、宏观趋势等。
为了能更好地赋能科学家的创业项目,启明创投合伙人陈侃表示启明创投搭建了比较完善的投后体系,包括项目管理、招聘、品牌和政府关系的支持。
具体来说,项目管理团队能给科学家推进内部项目以框架性建议;投后招聘团队能帮忙招高管和核心团队;政府关系团队能为企业提供一系列建议比如遗传资源报备、市场准入、政府项目申报、落地等。同时,项目团队能够提供战略、财务和融资方面的帮助。“这些帮助能够陪伴企业渡过最初的困难时期。后期,随着管理团队不断到位,公司的体系自然完整地建立起来。”
松禾资本创始合伙人罗飞则表示,松禾当下越来越倾向于投资平台型的公司。“在技术平台的基础上,我们希望看到这个团队也是一个相对复合的一个团队。”
博远资本创始合伙人陈鹏辉则会先看科学家创始人有没有正确的认知,其次看他有没有留出足够多的股权池。“我觉得这两点挺重要的。至于股权后面怎么分配,大家以一个公平合理或开放的心态来做这个事就比较好。”
创新工场执行董事暨前沿科技基金总经理任博冰表示,创新工场孵化或投资科学家主导的企业,往往会帮助团队提高工业界人士的比例,平衡科学家学术角色的同时,也给工业界一些经验补充。
“同时,企业内也未必是一个科学家主导,我们会尽可能提高多科学家合作、多技术交叉的比例。另外,相对中国市场而言,我们孵化或投资的企业大都是采用一个全球化的团队,从第一天开始就结合各地的人才和技术优势。不仅如此,项目的落地往往关注到更早期的深度合作,我们每年也会办一些大赛和培训营,为早期项目进行赋能新鲜血液和探索性技术。”
面对早期项目,一边是投资机构们的频频出手,另一边也存在科学家创业者拿钱的顾虑。
某布局孤儿药领域的创新药企创始人郑清教授表示,在创业过程中,他做过的最艰难抉择莫过于公司成立8年都未进行过一次对外融资。要知道,作为行业“老兵”,郑清教授曾用7年时间成功将一家生物科技公司从0做到在加拿大上市。在这个过程中,让他明白资本给一家生物医药公司发展同时带来的正向与负向压力。
所以在郑清教授看来,如果没有找到理念一致的资方,资本在寻求回报的过程中,原本由科学家掌控的研发步伐,有可能会被资本的力量推到另一个发展方向上。因此,找寻资本与研发进展的平衡点,显得尤为关键。
漫漫征途
创业,是一场九死一生的征途,而对于科学家项目来说,更是一场辛酸历程。但在重视创新驱动的当下,已然是不可逆的趋势。
从宏观层面看,近年来创新已被置于我国现代化建设中的核心地位。中国科学技术部数据显示,2021年,中国全社会研发投入达到2.79万亿元人民币,同比增长14.2%,研发投入强度(即研发投入占国内生产总值比重)达到2.44%,国家创新能力综合排名上升至世界第12位。可以看到,我国对于基础研究越来越重视。
这背后的原因有三。一是从经济发展的趋势走向看,全球的历史经验表明,世界上所有人均GDP接近或者达到1万美元的国家,必然都会走上科技创新的道路;二是从目前国际形势看,科技实力之间的竞争,已经成为了大国博弈的重要事项;三是底层技术的改变,也将带动各个产业的改变,从而带来更长效的经济增长。
“生物医药的创新,依赖于强大的基础研究。要增加生物医药投入,改革科研管理体制,尊重科学家首创精神,允许科学家个人享有部分权益,激励科学家发明创造的积极性。”在去年年底的一场论坛上,原国家食品药品监督管理总局局长毕井泉如此说道。
除了政策支持和行业大佬的呼吁外,已经功成名就的互联网大佬们也纷纷押注科学家项目。例如在2015年,百度公司创始人李彦宏,联想集团CEO杨元庆,真格基金创始人徐小平、北京大学教授饶毅等几位科学家、企业家组织创办了未来论坛,在这次论坛上,他们准备设立一个民间科学大奖。于是在2016年,未来科学大奖将正式宣布成立,该奖设置“生命科学”和“物质科学”、“数学与计算机科学奖”三大奖项,单项奖金100万美元。
杨振宁院士评价,未来科学大奖是第一个诞生于中国民间公益组织,由企业家群体发起成立的奖项,填补了中国民间权威科技奖项的空白。“瑞典有诺贝尔奖,香港有邵逸夫奖,而未来科学大奖作为后起之秀将产生更加深远的影响。”
在利好政策和市场环境的双重影响下,医疗领域当前正进入“科学家创业时代”,越来越多的科学家走出实验室,走向了创业场。
从科研成果转化的热度便可窥探。根据近期发布的《中国科技成果转化2021年度报告(高等院校与科研院所篇)》数据显示,2020年,全国3554家高校院所的合同项数为466882项,同比增长7.85%;合同总金额为1256.1亿元,同比增长15.67%。
但也要意识到,创业与科研的相似之处在于,创业看重的并不是“数量”,而是“质量”。因为只有那些真正具有原始创新性,且能满足临床需求的前沿技术,才能从实验室“走出来”,真正落地并得到市场的“认可”。所以,对于每一个入局者来说,这必将是一场漫漫征途。
无论怎样,医疗行业的新风口已经到来。而这些走向无人区的科学家创业者们,也终将在医疗创新大发展的历史中熠熠生辉。



评论